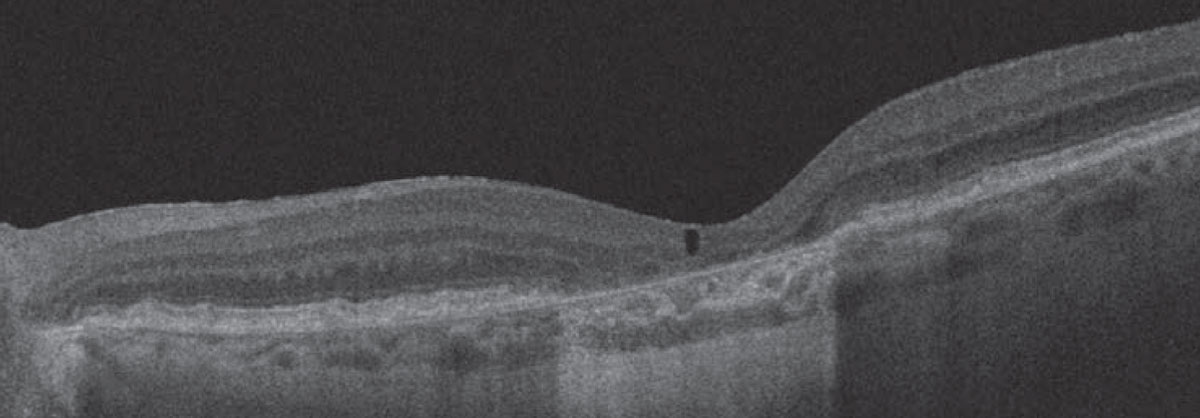

Take-home Points
|
![]() |
|
Bio Dr. Jeng-Miller is a graduating vitreoretinal surgery fellow at Tufts University/ Ophthalmic Consultants of Boston, with an appointment as an assistant professor in the department of ophthalmology and visual sciences at the University of Massachusetts Medical School, Worcester. DISCLOSURES: Dr. Jeng-Miller has no relevant financial relationships to disclose. |
Non-neovascular or nonexudative, or dry, age-related macular degeneration is defined as the presence of drusenoid deposits detected via clinical exam or ocular coherence tomography, without any associated choroidal neovascular membrane (CNVM). Drusen are characterized by extracellular debris that deposit between the retinal pigment epithelium and Bruch’s membrane.
While anti-VEGF therapy has revolutionized the treatment strategies and visual outcomes in patients with neovascular AMD, currently no Food and Drug Administration-approved treatments exist for visual decline in non-neovascular AMD.
The science of fluid in dry AMD
While subretinal (SRF) or intraretinal fluid (IRF) are established as indicators of neovascularization in AMD, it’s becoming increasingly evident that fluid may be present in cases of non-neovascular AMD. Thus, it’s important to recognize that fluid isn’t always a sign of neovascular activity. This differentiation is important for treatment decisions.
One hypothesis regarding this nonexudative fluid states that it may be due to transudative mechanisms, such as disrupted Müller cells or retinal pigment epithelial pump failure.1 Cystoid, or cavitary, spaces can occur over areas of atrophy as a result of the retinal degeneration process, possibly secondary to Müller cell degeneration (Figure 1).2
![]() |
| Figure 1. Optical coherence tomography demonstrates an area of subfoveal atrophy in a case of non-neovascular age-related macular degeneration with overlying cystoid degeneration. |
Mechanical strain from confluent drusen can also result in the appearance of SRF. In these cases, when confluent drusen are accompanied by subretinal spaces that appear filled with fluid, distribution of the fluid in the area between adjacent drusen may indicate that the group of coalescent drusen creates mechanical strain on the outer retinal layers, pulling the sensory retina away from its position.3 A 2020 study examined three different patterns of subretinal fluid in non-neovascular AMD that progress to collapse and atrophy:1
- fluid at the apex of a large drusenoid pigment epithelial detachment;
- fluid at the crypt between confluent drusen; and
- low-lying drape of fluid over confluent drusen (Figure 2). As a result, distinguishing between fluid that’s secondary to neovascular or non-neovascular processes is critical for making appropriate treatment decisions and avoiding unnecessary anti-VEGF therapy.
![]() |
| Figure 2. Three cases of non-neovascular age-related macular degeneration illustrating drusenoid pigment epithelial detachment (PED) and drusen associated with three different patterns of subretinal fluid (SRF) that progress to collapse and atrophy.1 A) Spectral-domain optical coherence tomography illustrates drusenoid PED with crest of SRF associated with an acquired vitelliform lesion and focal retinal pigment epithelium thickening, including intraretinal hyper-reflective foci. B) At the five-year follow-up visit, the drusenoid PED is collapsed with development of complete RPE and outer retinal atrophy (cRORA). C) SD-OCT illustrates drusenoid PED with SRF located at the angle or crypt of the PED. D) At the 10-month follow-up visit, the PED is collapsed with progression to cRORA. E) SD-OCT illustrates drusenoid PED with low-lying drape of SRF. F) At the seven-year follow-up visit, the drusenoid PED is collapsed with progression to cRORA. (Figure courtesy Assaf Hilely, MD. Reprinted with permission BMJ Publishing Group). |
![]() |
The role of OCT and FA
OCT has become a critical tool in the diagnosis and evaluation of AMD. Drusen can sometimes be very subtle during a clinical exam. OCT helps to visualize and evaluate these fine drusen so disease classification and management can proceed. If an OCT image reveals no associated fluid, it’s more likely that a CNVM isn’t present and further ancillary testing is unnecessary.
Concern for SRF or IRF increases the possibility of a CNVM. Fluorescein angiography is helpful in confirming the presence of a CNVM, thus informing the diagnosis and treatment recommendation. Performing FA may not only be confirmatory, but may also help the patient understand the need for treatment, which is particularly valuable given the hesitance and concerns that may exist regarding intraocular injections.
While the risks for serious complications related to anti-VEGF therapy are low, the time and psychological burdens on the patient are significant. When a patient understands more about their disease process, it may help with treatment receptivity.
OCT angiography has also become a useful tool in evaluating the presence of a CNVM. Often, CNVM can be seen on the en face OCTA or flow can be present on the B-scan, suggesting the presence of a CNVM.
However, limitations in OCTA often lie in projection artifacts. As the technology improves, it’s likely this method of imaging will become more widely employed in daily diagnostic questions.
Diagnostic strategies and challenges
In differentiating between non-neovascular and neovascular AMD, it’s important to look at the entire clinical picture: clinical exam; ancillary imaging; and patient subjective complaints.
On examination, the presence of a gray-ish subretinal elevation or hemorrhage can point you toward a diagnosis of CNVM. It’s also important to ascertain whether or not these patients have symptoms, such as distortions, new blind spots or any other change in vision. These findings, in conjunction with OCT, and possibly OCTA and FA testing, can help determine the true etiology of the fluid and guide treatment options.
![]() |
Not all SRF is bad
Remember that not all SRF is bad. Cases of persistent or residual SRF accompanied by better visual acuity have been reported,4 thus suggesting a functioning, albeit impaired, RPE pump.5 This is in contrast to cases of RPE and outer retinal atrophy without fluid with accompanying poor vision where fluid is cleared by passive mechanisms due to the absence of the normally functioning RPE and outer retinal barriers.5
When the findings aren’t definitive, it’s important to discuss treatment options with the patient, including the possibility of a trial injection and follow-up assessment. This strategy mitigates unnecessary treatment burden while avoiding the risks associated with no treatment or loss to follow-up, resulting in vision loss.
Bottom line
Non-neovascular AMD with SRF is an increasingly recognized entity that can be difficult to distinguish from nAMD. Intravitreal injection therapy for nAMD has revolutionized the treatment paradigm, but the time, cost and psychological burdens on the patient aren’t insignificant.
So, it’s important that physicians are aware that fluid may be present in non-neovascular AMD and avoid reflexive unnecessary anti-VEGF therapy. The use of OCT, OCTA and FA to verify the presence of a CNV membrane becomes increasingly important in helping to differentiate these entities and guiding patient management. RS
REFERENCES
1. Hilely A, Au A, Freund KB, et al. Non-neovascular age-related macular degeneration with subretinal fluid. Br J Ophthalmol. Published online September 12, 2020. doi:10.1136/bjophthalmol-2020-317326.
2. Cohen SY, Dubois L, Nghiem-Buffet S, et al. Retinal pseudocysts in age-related geographic atrophy. Am J Ophthalmol. 2010;150:211-217.
3. Sikorski BL, Bukowska D, Kaluzny JJ, Szkulmowski M, Kowalczyk A, Wojtkowski M. Drusen with accompanying fluid underneath the sensory retina. Ophthalmology. 2011;118:82-92.
4. Roh M, Miller JW, Jeng-Miller KW, et al. Subthreshold exudative choroidal neovascularization associated with age-related macular degeneration identified by optical coherence tomography angiography. J Vitreoretin Dis. 2020;4:377-385.
5. Sharma A, Kumar N, Parachuri N, et al. Understanding the mechanisms of fluid development in age-related macular degeneration. Ophthalmol Retina. 2021;5:105-107.